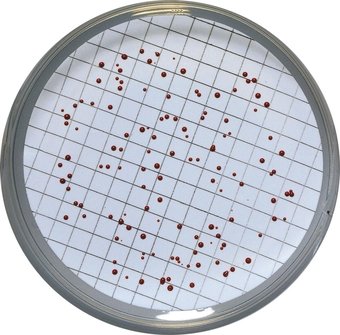
Análisis Microbiológicos

El Servicio de Valoración Toxicológica y Medio Ambiente del INTCF constituye una herramienta fundamental en la resolución de supuestos Delitos contra el Medio Ambiente.
Su labor pericial es clave para la determinación de la gravedad de las agresiones procedentes de vertidos de distinta naturaleza a los ecosistemas naturales. En este sentido emite Informes periciales, solicitados por las Autoridades Judiciales y Fiscalías de Medio Ambiente, en el curso de las actuaciones judiciales o en diligencias previas de investigación efectuadas por el Ministerio Fiscal.
Las muestras para análisis, son
tomadas y remitidas al INTCF por la policía judicial especializada, como es el caso de la Guardia Civil (ECOMA y SEPRONA), Policías Autonómicas y Agentes Forestales y Medioambientales, asesorados, siempre que se requiera, por los Facultativos del Servicio.

En ocasiones, la Autoridad Judicial requiere un Informe de Valoración de análisis o Informes realizados por otros laboratorios, privados u oficiales, siempre en el curso de investigaciones judiciales.
Los Tipos de investigaciones que se realizan se encaminan fundamentalmente a:
Estudio de afectación medioambiental por vertidos de aguas residuales urbanas o industriales.Estudio de afectación medioambiental por vertidos de purines y lodos de depuradora.
Análisis y Valoración Toxicológica de Residuos y Lixiviados.
Análisis y Valoración Toxicológica de contaminantes en suelos.
Trabajo de campo


Técnicas Físico-químicas

Medida del pH por técnicas electroquímicas
Medida de la Conductividad por técnicas electroquímicas
Determinación de la Salinidad por técnicas electroquímicas
Determinación de la Dureza del agua por complexometría
Determinación de la Alcalinidad total por volumetría
Pérdida de peso a 105º C por gravimetría
Determinación de Sólidos en Suspensión por gravimetría
Determinación de Sólidos Sedimentables mediante el cono Imhoff
Determinación de DBO5 por el método de dilución y siembra
Determinación de DQO por fotometría de absorción molecular mediante el método del dicromato potásico.
Determinación de la Oxidabilidad por volumetría.
Determinación de Tensoactivos aniónicos por el método de azul de metileno
Determinación de Fenoles Totales por espectrofotometría
Determinación de Aceites y grasas por gravimetría
Determinación de Nitratos mediante electrodo selectivo
Determinación de Fluoruros mediante electrodo selectivo
Determinación de Carbono Orgánico Total, Carbono Total y Carbono Inorgánico disueltos, por el método de oxidación por combustión catalítica y detección por IR.
Determinación de Nitrógeno Total disuelto, por combustión catalítica, oxidación y detección por quimioluminiscencia.
Determinación de Fósforo, por espectroscopia de emisión con plasma acoplado inductivamente.
Determinación de Metales (aluminio, arsénico, bario, boro, calcio, cadmio, cobre, estroncio, hierro, magnesio, manganeso, níquel, plomo, potasio, sodio y zinc), por espectroscopia de emisión con plasma acoplado inductivamente.
Determinación de Cromo VI por espectrofotometría de absorción molecular.
Determinación de Mercurio por espectrometría de fluorescencia atómica.
Estudios de Ecotoxicidad

Ensayo de inhibición de la fluorescencia de Vibrio fisheri
Toxicidad aguda en Daphnia magna
Ensayo de inhibición del crecimiento del alga Chlorella vulgaris
Análisis Microbiológicos
Indicadores de contaminación fecal: Coliformes Totales, Escherichia coli, Streptococos fecales, mediante el método de filtración en membrana
Estudio Documental y de Valoración de Resultados analíticos

Cada Departamento cuenta con un Jefe de Servicio y Facultativos de la especialidad de Valoración Toxicológica y Medio Ambiente, Técnicos especialistas de Laboratorio (TEL) y Ayudantes de Laboratorio.
Acreditación ENAC:
La competencia técnica y la calidad de los resultados analíticos generados por el Servicio son evaluados permanentemente, según las normas de Calidad del Centro, estando acreditados desde el año 2008, conforme a la Norma ISO 17025, por la
Entidad nacional de Acreditación (ENAC), para la realización de ensayos en el sector medioambiental, área de muestras medioambientales líquidas: Aguas continentales, residuales y Residuos líquidos, para el ensayo de Inhibición de la bioluminiscencia bacteriana con Vibrio fischeri (Toxicidad CE50) (acreditación 297/ LE1366).
Definición e implantación de un sistema de calidad según la norma ISO 17025, para asegurar la competencia técnica y la calidad de los resultados analíticos generados en este Servicio.
Realización de procedimientos normalizados de trabajo tanto de técnicas como de equipos y su mantenimiento, calibración y verificación, desarrollo y validación de métodos.
Acreditado por la
Entidad nacional de Acreditación (ENAC), conforme a los criterios recogidos en la Norma UNE-EN ISO/IEC 17025: 2005 (CGA-ENAC-LEC) desde el año 2008, para la realización de:
Ensayos en el sector medioambiental. ÁREA DE MUESTRAS MEDIOAMBIENTALES LÍQUIDAS
Aguas continentales
Inhibición de la bioluminiscencia bacteriana con Vibrio fischeri (Toxicidad CE50)
(45% - 0,1%)
Procedimiento interno
PNT-V-T013
Aguas residuales
Inhibición de la bioluminiscencia bacteriana con Vibrio fischeri (Toxicidad CE50)
(45% - 0,1%)
Procedimiento interno
PNT-V-T013
Lixiviados
Inhibición de la bioluminiscencia bacteriana con Vibrio fischeri (Toxicidad CE50)
(45% - 0,1%)
Procedimiento interno
PNT-V-T013
Residuos líquidos
Inhibición de la bioluminiscencia bacteriana con Vibrio fischeri (Toxicidad CE50)
(45% - 0,1%)
Procedimiento interno
PNT-V-T013
Participación en ensayos de intercomparación:
LGC Standars Proficiency Testing: Aquacheck Analitos no especificos:
DBO5, DQO, MBAS, COD/COT, Sólidos en Suspensión.
Metales:As, Al, Cr, Fe, Mn, Cd, Cu, Pb, Ni, Zn y Se y Cr VI.
Laboratory Environmental Analysis Proficiency (LEAP): Programa de ensayos de aptitud de aguas de consumo, residuales, tierras y residuos peligrosos:
pH, Conductividad eléctrica; Nitratos, Fósforo total, Nitrógeno total; Aceites y Grasas; Alcalinidad, Calcio, Dureza total, magnesio, sodio, potasio; Sólidos Sedimentables.
Universidad Politécnica de Cataluña (UPC):
Ensayo de Toxicidad con bacterias luminiscentes.
Evaluación interna de la Calidad, mediante patrones y materiales de referencia certificados
Participación en cursos de formación en el ámbito de la Administración de Justicia:
Cursos de acceso a la Carrera Judicial.
Cursos de acceso a la Carrera Fiscal.
Cursos de acceso al Cuerpo Nacional de Secretarios Judiciales.
Cursos de acceso al Cuerpo Nacional de Médicos Forenses.
Plan estatal de formación continuada del cuerpo Nacional de Médicos Forenses organizado por el Centro de Estudios Jurídicos.
Cursos de Formación continuada del Cuerpo Nacional de Fiscales.
Participación en cursos de formación en el ámbito de las Administraciones Públicas:
Jornadas Teórico-Prácticas sobre metodología de Toma de muestras medioambientales dirigidas a Agentes Forestales.
Curso de formación de promoción interna de la 1ª promoción de Agents Rurals de Catalunya.
Cursos de Investigación de Delitos Medioambientales organizados por la Fiscalía de Medioambiente de Catalunya con la participación del INTCF, desde el año 1998.
Colaboración con la Sección de Toxicología Ambiental de la Asociación Española de Toxicología (AETOX).
Colaboración con el Instituto Universitario de Investigación en Ciencias Policiales de la UAH.
Participación en Tribunales de Tesis Doctorales.
Participación en Tribunales de Oposiciones para Cuerpos Especiales del INTCF.
Revisión de artículos para publicación en diferentes revistas científicas.
Consejerías de Medio Ambiente de las Comunidades Autónomas
